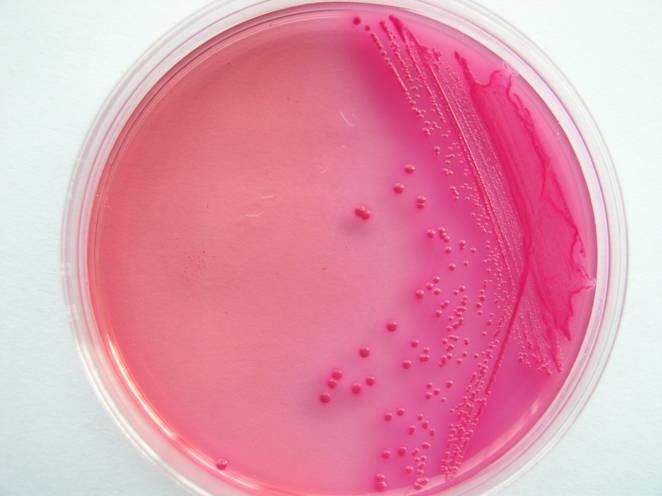

海博微信公众号
海博微信公众号
 海博天猫旗舰店
海博天猫旗舰店


 海博微信公众号
海博微信公众号
 海博天猫旗舰店
海博天猫旗舰店




A、定义:大肠菌群是一类发酵乳糖产酸产气的革兰氏阴性无芽孢杆菌。
B、培养基:去氧胆酸盐琼脂、VRBA琼脂、LST肉汤、BGLB肉汤、胆盐乳糖发酵培养基、乳糖蛋白胨培养液、品红亚硫酸钠琼脂(ENDO培养基)、MFC琼脂。
在常规方法中,主要用以上培养基,还可以用大肠菌群显色培养基,可以快速检测大肠菌群。本公司就生产大肠菌群显色培养基。
去氧胆酸盐琼脂:
配方(g/L):
蛋白胨 10.0
乳糖 10.0
去氧胆酸钠 1.0
磷酸氢二钾 2.0
柠檬酸铁 1.0
柠檬酸钠 1.0
中性红 0.03
氯化钠 5.0
琼脂 15.0
pH 7.3±0.2 25℃
其中蛋白胨提供氮源;乳糖提供碳源;去氧胆酸钠是一种抑菌剂,主要抑制革兰氏阳性菌的生长;磷酸氢二钾是一种缓冲体系;柠檬酸铁和柠檬酸钠是一种生长促进剂;中性红是一种指示剂,在酸性时呈红色,当大肠菌群发酵乳酸时产生酸性物质,所以菌落呈红色;氯化钠是维持细菌生长时的渗透压;琼脂是一种凝固剂。海博生物公司生产的去氧胆酸盐琼脂,采用本公司生产的特殊蛋白胨,所以营养特别丰富,大肠菌群生长迅速。与国外培养基质量处于同一品质。
上一篇:金黄色葡萄球菌检测注意事项



